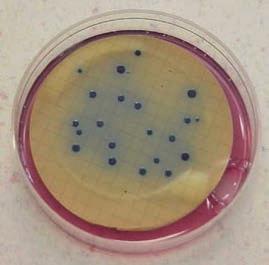

1 minute read
Indicator Bacteria Testing Methods
The detection and enumeration of disease-causing organisms (pathogens) identified with waterborne illness is difficult, time-consuming and costly. Thus, most water quality laboratories are required to test for fecal indicator bacteria (i.e., total coliforms, fecal coliforms and enterococci) as a means to ascertain the likelihood that human pathogens may be present in recreational waters. Fecal indicator bacteria normally occur in the intestines of all warm-blooded animals, are excreted in high numbers in feces, but can also be found in soil and decaying vegetation. Since there is no ideal indicator group, testing is done for more than one indicator. Total coliforms are a broad group of organisms that include fecal coliform bacteria as well as E. coli The enterococci group has been determined to be a good indicator of water-contact associated gastroenteritis. The methods most commonly used to detect fecal indicator bacteria in water include:
• Membrane Filtration (MF)
Advertisement
• Multiple-Tube Fermentation (MTF)
• Colilert®
• Enterolert®
All of the methods are culture based, which means that the indicator bacteria present in water must be allowed to grow in order to be detected. Differences between the methods include how the bacteria are detected and counted, how soon the results become known, and cost. Each method has its advantages and disadvantages. Most of the limitations depend on factors such as the other types of constituents in the water and density of bacteria present, and all require at least an 18-hour incubation period. The following is a brief summary of the Membrane Filtration method, the method used by the County of Orange Health Care Agency/Public Health Laboratory, the South Orange County Wastewater Authority Laboratory and the Orange County Sanitation District Laboratory for the analyses of total coliforms, fecal coliforms and enterococci in ocean and bay waters. Detailed descriptions for the Membrane Filtration (MF), MultipleTube Fermentation (MTF), Colilert® and Enterolert® methods are available in the latest edition of Standard Methods for the Examination of Water and Wastewater.
Membrane Filtration (MF)
The Membrane Filtration method involves filtering water through a porous membrane to concentrate or trap bacteria from the water sample on the filter surface. The membrane filter is placed onto a culture medium designed to encourage the growth of the target indicator. The filter is incubated for 22–24 hours to allow the bacterial cells to multiply into visible colonies. Theoretically, each bacterial cell (or clump of cells) produces a single colony on the membrane.
The colonies are viewed under a 10X magnifying lens and distinguished from non-target bacteria based on the type, size and color of the colonies. Target bacteria are indicated by pigment production resulting from bacterial enzymatic reactions to specific substrates. The number of colonies present in 100 milliliters of water, also known as “Colony Forming Units” (CFUs), is counted and the concentration of organisms in the original sample is calculated.